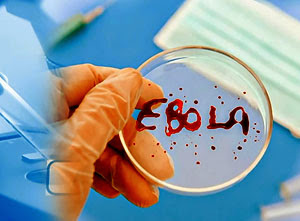
Вирус Эбола Вирус Эбола

Последнее время все средства массовой информации говорят об эпидемии опасного вируса Эбола. Люди в страхе и в панике.
Заболевание Эбола, безусловно, очень страшное, но если хорошо подумать и оставить эмоции, то становится ясно, что нагнетание африканского вируса напоминает историю со свиным гриппом, в результате от него умирало гораздо меньше людей, чем умирают от привычных ОРВИ.
Всемирная организация здравоохранения объявила заболевание Эбола угрозой международного масштаба. Многих мучает вопрос не разнесется ли эта болезнь по всему миру, как чума или оспа. Давайте попробуем разобраться возможно ли заболевание Эбола в России как от него защититься?
Распространение вирусного заболевания Эбола
Заболеть лихорадкой Эбола не так просто, как обычными вирусами, ведь воздушно-капельным путем он не передается.
Заражение может быть только:
- через слизистые оболочки;микро травмы кожи;
- через контакт с кровью;
- через выделения организма;
- при контакте с загрязненными медицинскими инструментами, шприцами, иглами;
- при поедании экзотических животных, например летучих мышей, считающихся в Африке деликатесом.
Заболевание Эбола не грипп, так просто от человека к человеку не переходит. Самый большой риск у медицинских работников, которые ухаживают за больными и не следуют правилам безопасности. Потенциал для обширного распространения считается низкой.
Врачи отмечают, что риск возникновения заболевания Эбола в России остается низким, однако не исключен. Основные факторы, способствующие распространению вируса, связаны с международными поездками и контактами с зараженными. Специалисты подчеркивают важность контроля за прибывающими из эндемичных регионов, а также необходимость повышения осведомленности населения о симптомах и мерах предосторожности. В случае появления первых признаков заболевания, медики рекомендуют немедленно обращаться за медицинской помощью. Важно также отметить, что российская система здравоохранения готова к возможным вызовам, имея необходимые ресурсы и протоколы для диагностики и лечения. В целом, врачи уверены, что при соблюдении мер предосторожности и внимательном отношении к ситуации, вероятность вспышки остается минимальной.

Симптомы заболевания Эбола
При попадании в кровь вирус никак не проявляется от 2 дней до 3 недель.
Далее у заболевшего могут быть следующие симптомы заболевания Эбола:
- слабость, упадок сил
- сильные головные боли
- боли в животе
- мышечные боли
- рвота, диарея тошнота
- признаки ангины
- высокая температура.
Затем наблюдаются кожные и внутренние кровоизлияния, кровавая рвота, понос , сухой кашель, боли в груди, обезвоживание организма, патологии в органах — пневмония, гепатит, панкреатит. Анализ крови показывает нейтрофильный лейкоцитоз, анемию, тромбоцитопению.
Смерть наступает через 2 недели от кровотечений и инфекционно — токсических шоков.
Причины заболевания лихорадкой Эбола
Лихорадка Эбола с февраля по август унесла жизни 3431 человека. Общее число заразившихся 7470 человек. Во время нынешней эпидемии смертность не превышает 50%, то есть каждый второй выживает.
Главное это вовремя оказанная медицинская помощь, также возраст, генетика, наличие у больного других заболеваний. Лечение заключается в повышении иммунитета, облегчении симптомов, чтобы организм сам смог справиться с вирусом.
Если иммунитет борется с болезнью, то Эбола длится — две три недели, а потом два три месяца период восстановления.
Главной причиной заболевания лихорадкой Эбола в самых бедных районах Африки считается страшная антисанитария.
Используются многоразовые шприцы, дезинфицируют их несколько раз в неделю.
Едят не прожаренных животных, например мышей, которые могут быть заражены этим вирусом.
Питьевая вода очень грязная.
При таких антисанитарных условиях Африка если и вымрет, то уж точно ни от африканской Эболы.
Заболевание Эбола вызывает у людей множество вопросов и опасений, особенно в странах, где этот вирус не распространен. В России, несмотря на отсутствие случаев заболевания, общественное мнение разделено. Многие россияне считают, что с учетом глобализации и увеличения международных поездок риск заражения может возрасти. Однако эксперты уверяют, что система здравоохранения и санитарные меры в стране способны предотвратить вспышку. В социальных сетях активно обсуждаются меры предосторожности, и некоторые призывают к повышению осведомленности о симптомах и профилактике. В то же время, другие выражают скептицизм, полагая, что паника вокруг Эболы преувеличена. Важно помнить, что информация и образование играют ключевую роль в формировании адекватного восприятия угрозы.

Грозит ли эпидемия заболевания лихорадкой Эбола России?
Гигиена против вируса.
- При уходе за больными нужно надевать перчатки и защитные маски.
- После посещения больных сразу мыть руки.
- Не совершать покупки в местах несанкционированной торговли.
- При появлении симптомов срочно обратиться к доктору.
Самое главное правило профилактики Эболы — соблюдение гигиены и чистоты.
Вероятность заболевания Эболы в России мала. Зараженные опасны только тогда, когда у них уже проявляются симптомы болезни. Сейчас применяются универсальные меры защиты, если даже заболевшие и попадут на нашу территорию, то они не смогут стать источником передачи вируса. Люди приезжающие из районов, где зафиксированы случаи заболевания сразу изолируются на карантин на 3 недели.
Эпидемический надзор в России не спит. Новые разработки в диагностике позволяют распознать вирус на ранних стадиях.
Совсем недавно министр здравоохранения озвучила полугодовой период создания вакцины против Эболы. Уже сейчас своевременное лечение дает 90% выздоровление.
Вывод: что касается заболевания Эболы, то выигрывает, как всегда, фармакологический бизнес. В России строгий контроль по предотвращению вирусных эпидемий. Так что нам россиянам бояться не стоит.
Берегите себя и будьте здоровы!
Вопрос-ответ

В каком году была Эбола в России?
Этой радостной новостью поделился президент Владимир Путин во время встречи с членами правительства. Впервые вспышка лихорадки была зафиксирована в Заире в пойме реки Эбола, отсюда и название вируса. Тогда жертвами стали более 300 человек.
Где сейчас есть Эбола?
Существует эффективная вакцина против заирского штамма вируса Эбола, который в основном встречается в Гвинее и Демократической Республике Конго.
Когда была последняя вспышка Эболы?
Прошло 42 дня с момента последнего зафиксированного случая заражения. ВОЗ объявила о завершении вспышки вируса Эбола.
Где распространен вирус Эбола?
Ebola haemorrhagic fever (EHF, лат. Ebola febris haemorrhagica) — острая вирусная высококонтагиозная болезнь. Редкое, но крайне опасное заболевание. Вспышки эпидемии зафиксированы в Центральной и Западной Африке. Летальность составляла от 25 до 90 % (в среднем 50 %).
Советы
СОВЕТ №1
Следите за новостями и официальными источниками информации о ситуации с заболеванием Эбола. Министерство здравоохранения и другие государственные организации регулярно обновляют данные о возможных случаях и мерах предосторожности.
СОВЕТ №2
Изучите симптомы заболевания Эбола и будьте внимательны к своему здоровью. Если вы заметили у себя или окружающих симптомы, такие как высокая температура, головная боль или рвота, немедленно обратитесь к врачу.
СОВЕТ №3
Избегайте поездок в регионы, где зарегистрированы случаи заболевания Эбола, если это возможно. Если вам необходимо поехать, ознакомьтесь с рекомендациями по безопасности и мерам предосторожности.
СОВЕТ №4
Поддерживайте личную гигиену и соблюдайте правила санитарии. Регулярно мойте руки с мылом, используйте антисептики и избегайте контактов с людьми, у которых есть симптомы заболевания.